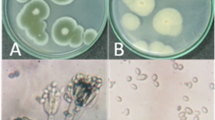

Abstract
Biodegradation of biphenyl was carried out by Rhodococcus erythropolis T902.1 in presence of nanometer-sized metallic (Co, Pd, Ag and Cu) nanoparticles (NPS) synthesized by the sol–gel process. In order to prevent their agglomeration, the metallic NPs (1–2 nm diameter) were anchored inside microporous silica crystallites and named Co/SiO2, Pd/SiO2, Ag/SiO2 and Cu/SiO2 samples, respectively. They were added at low concentrations of 10−6, 10−5 and 10−4 M of metal in the culture medium, and their impact was compared with that of the simple metal ions added as cobalt, palladium, silver or copper salts. The cultures containing Pd/SiO2 or Co/SiO2 samples at 10−4 M of metal achieved a 50 % higher biphenyl degradation yield after 18 days of incubation and improved R. erythropolis T902.1 growth compared with those without (positive control) or with silica particles only. The highest biodegradation performance, i.e., 107 ± 3 ppm/day, which was about 85 % higher than in control conditions without NPs, was recorded in 250-mL baffled flasks stirred at 150 rpm with Co/SiO2 sample at 10−4 M Co. Furthermore, the stimulating effect of NPs on biphenyl biodegradation seems to also depend on the thermal treatment conditions applied to NPs since the experimental results indicated that, after calcination, the cobalt oxide NPs at a concentration of 10−4 M were more effective than the reduced cobalt NPs with a degradation yield of 81 ± 1 and 77 ± 2 %, respectively, after 18 days. On the other hand, the results showed that the addition of 10−4 M of Cu2+ or Ag+ ions or the addition of Cu/SiO2 or Ag/SiO2 samples at 10−4 M of metal have an inhibitory effect on biphenyl biodegradation. However, Cu2+ and Ag+ ions were more toxic to the R. erythropolis T902.1 bacteria than the respective Cu or Ag NPS anchored inside silica particles. Moreover, this work showed that in these conditions, the activity of catechol 1,2-dioxygenase (a critical enzyme in aromatic biodegradation pathway) was severely inhibited, whereas the presence of 10−4 M of Co2+ ions or Co/SiO2 sample stimulated the enzyme activity compared to the conditions without NPs.
Graphical Abstract

Similar content being viewed by others
Explore related subjects
Discover the latest articles, news and stories from top researchers in related subjects.Avoid common mistakes on your manuscript.
1 Introduction
Polycyclic aromatic hydrocarbons (PAH) such as biphenyl, fluorene, phenanthrene, anthracene, and fluoranthene are worldwide manufactured and used in a variety of industrial processes and products such as fungicides and pesticides [1, 2]. Therefore, large amounts of these compounds or derivatives are diffused in ground waters and soils [3, 4]. Due to their carcinogenic, genotoxic and mutagenic properties, PAH were widely studied regarding their environmental effects [5–7].
For some decades, different physico-chemical techniques were used for the treatment of wastewater and soil contaminated with PAH, i.e., ozonation, adsorption, solvent extraction, Fenton effects and photodegradation in presence of iron [8–10]. Biological methods are also available for the reduction of aromatic pollutants though they need a longer process time. These methods are based on the potential of some microorganisms to use the pollutants for growth and source of energy [11, 12]. Compared with physico-chemical methods, the PAH biodegradation methods are preferred because of lower costs and their potential to degrade almost completely the pollutants without release of toxic end-products in the environment. Indeed, the physico-chemical techniques are relatively expensive and they frequently produce toxic and undesirable products that require further treatment steps [13, 14].
Numerous studies have demonstrated that many PAH can be biodegraded under aerobic or anaerobic conditions by different microorganisms such as Pseudomonas species [15–17], Mycobacterium [18–20], Nocardioides [21], Citrobacter freundii BS2211 [22] and Rhodococcus [8, 23–25]. However, most of the PAH are stable and highly hydrophobic, thus having a low availability for microorganisms since they need an aqueous environment for their growth. As a consequence, bioremediation processes are very limited. Long time periods of a few weeks to a few months are required for microbial degradation of highly hydrophobic substances [26].
Several strategies have been proposed to accelerate bioremediation processes using mixed cultures of suspended bacteria [27], cell immobilization [11, 28] or genetically engineered microorganisms [12]. Furthermore, the addition in the microbial environment of a conventional carbon source such as ethanol or glucose as co-substrate [11, 29] and of nitrogen sources [3, 29] was often reported to promote growth and biodegradation performances. Moreover, numerous studies have demonstrated that bioremediation can be accelerated with some metals at low concentrations [8, 30, 31]. Aldric et al. [30] showed that the presence of iron at concentrations up to 10−3 M increased the degradation of isopropylbenzene by Rhodococcus erythropolis T 902.1. Sridevi el al. [31] also reported that the presence of 0.01 g/L of Co2+, 0.02 g/L of Mn2+ or Cu2+ ions (i.e., 1.7 × 10−4, 3.6 × 10−4 and 3.1 × 10−4 M, respectively) enhanced the phenol biodegradation yield by Pseudomonas putida NCIM 2102. On the other hand, Bunescu et al. [8] studied the degradation of 2-aminobenzothiazole (ABT) under various conditions: (1) a photodegradation process with UV light in presence of Fe(III)-nitrilotriacetic acid (FeNTA) only, (2) a biodegradation process using Rhodococcus rhodochrous OBT18 with FeNTA at concentrations ranging from 10−4 to 10−3 M and (3) the combined processes (FeNTA plus R. rhodochrous in presence or absence of UV light). The degradation of ABT in the combined system, with or without UV light, was more efficient (99 % degradation after 25 h) than in the separated systems (respectively 37 % photodegradation and 26 % biodegradation after 125 h). It is also reported that the presence of FeNTA increased the biodegradation of ABT without any inhibition up to 5 × 10−4 M FeNTA. Metallic or metallic oxide nanoparticles (NPs) represent a new generation of compounds to improve environmental remediation and biological processes [10, 32, 33]. They could provide solutions to some of the most challenging environmental clean-up problems. The use of iron and/or palladium NPS is very effective for the biodegradation of a wide variety of common environmental contaminants, such as chlorinated organic solvents and polychlorinated biphenyls or PCBs [33, 34]. However, some environmental issues still need to be addressed, for instance in relation with the potential internalization and bioaccumulation or NPs in organisms cells, particularly increased due to their very small size [35]. In order to prevent these mechanisms and also to avoid NPs agglomeration reducing their specific area, different methods have been developed such as the sol–gel process. It is based on the encapsulation of metallic or metallic oxide NPs inside a porous matrix like silica by the cogelation method [36–40]. Using this process, Mahy et al. [10] showed that the presence of 10−4 M of iron NPS anchored inside porous silica matrix, with UV light/H2O2 system was able to degrade 10−4 M of p-nitrophenol after 24-h incubation in aqueous medium.
This sol–gel chemical synthesis method is based on the concomitant hydrolysis and condensation of tetraethoxysilane [TEOS, Si(OC2H5)4] with a modified alkoxide of formula (RO)3Si-XL, in which the ligand L is able to form a complex \(({\text{LM}})_{\text{n}}^{{{\text{m}} + }}\), with a metallic cation Mm+ (such as Pd2+, Ag+, Pt2+,…) and that is connected to the alkoxide (RO)3Si- moiety through an inert and hydrolytically stable organic group, X. After heat treatments of texture of xerogel (drying, calcination and reduction), metallic nanoparticles (2–3 nm) are homogeneously dispersed through the silica matrix. [36–40]. The experiments reported in this paper were carried out with different metallic NPs anchored inside porous silica synthesized using TEOS as silica precursor and 3-(2-aminoethylamino) propyltrimethoxysilane [EDAS, (CH3O)3Si(CH2)3NH(CH2)2NH2] as the modified alkoxide. According Alié et al. [41, 42], the ligand EDAS initiated a nucleation process as its hydrolysis and condensation reactions are faster than that of TEOS. So hydrolyzed EDAS molecules can act as a nucleation agent leading to silica particles with hydrolyzed EDAS core and principally made of hydrolyzed TEOS. The proof of anchored metallic particles into the silica matrix was obtained by electron tomography and rotating transmission electron microscopy [43–46]. These methods applied on Pd/SiO2 samples demonstrate that the palladium particles are localized deep inside the silica skeleton. The metallic particles are regularly spaced in the middle of the silica skeleton, with a distance between them comparable to the diameter of the struts of silica.
Therefore, the goal of this work was to investigate the inhibitory or stimulating effect of metal NPs anchored in silica matrix (Cu/SiO2, Ag/SiO2, Pd/SiO2 or Co/SiO2) or metal ions (Co2+, Cu2+ or Ag+) at concentrations ranging from 0 (positive control) to 10−4 M of metal element on the rate of biphenyl degradation by R. erythropolis T902.1.
2 Materials and methods
2.1 Preparation of concentrated suspensions of metal nanoparticles and concentrated solutions of metal ions
The samples Co/SiO2, Pd/SiO2, Cu/SiO2 and Ag/SiO2 are prepared by the sol–gel method, as described by Lambert et al. [47]. This method consists of (1) the preparation in one step (the cogelation method) of the porous silica from TEOS, in which metallic complexes Mn+[NH2–CH2–CH2–NH–(–(CH2)3–Si (OCH3)3]n are homogeneously dispersed at molecular level; (2) the drying under vacuum to remove solvent; and (3) the thermal treatments like calcination to remove organic moieties and reduction to reduce metallic ions into the corresponding metals. After the different steps of preparation, the samples are characterized by using the methods described by Lambert et al. [38, 47, 48] and Heinrichs et al. [43, 44]. For the clarity of this study, Co/SiO2, Pd/SiO2, Cu/SiO2 and Ag/SiO2 samples are used as notations and are defined as corresponding metallic NPs anchored inside porous silica after vacuum drying, calcination and reduction steps.
For all metallic NP, a 10−3 M concentrated suspension in ultrapure water was prepared in 50-mL bottles by finely pounding (at micrometre size) and weighing some Cu/SiO2, Ag/SiO2, Pd/SiO2 and Co/SiO2 sample, i.e., 0.079, 0.316, 0.160 or 0.147 g, respectively. According to the experimental conditions, a defined volume of homogenized suspension was transferred in the culture medium prior to sterilization in order to reach a final concentration of Cu, Ag, Pd or Co equal to 10−4, 10−5 or 10−6 M. An equivalent SiO2 suspension without metal was also prepared in 50 mL ultrapure water using 0.0030 g of SiO2 sample synthesized by the sol–gel process [47] in order to check whether silica plays a significant role in the biodegradation of biphenyl. In the same time, 0012 g of CoCl2·6H2O, 0009 g of CuCl2·2H2O or 0008 g of AgNO3 were added under stirring in 50 mL ultrapure water in order to obtain concentrated solutions of 10−3 M of metal ions (Co2+, Cu2+ or Ag+).
2.2 Culture
A preculture was prepared in 250-mL baffled flasks containing 50 mL of M284 minimal medium [49] complemented by 5 g/L of glucose. The medium was sterilized for 20 min at 121 °C and cooled down to room temperature before inoculation at an initial cell density of about 109 cell/mL by transfer of colonies of R. erythropolis T902.1 developed on M284 + agar medium. The microbial suspension was incubated for 3 days at 30 °C and 150 rpm orbital agitation. The glucose was totally consumed after 3 days of incubation (assayed by the Kit RTU glucose, BioMérieux, F). For the biphenyl biodegradation experiments, the culture medium was prepared similarly in 100-mL flasks or 250-mL (in triplicates) baffled flasks with 20 mL of M284 supplemented with dried, calcined or reduced Ag/SiO2, Cu/SiO2, Pd/SiO2, Co/SiO2 and SiO2 samples or Ag+, Cu2+, Co2+, Pd2+ ions at concentrations ranging from 0 (positive control) to 10−4 M of metal element. After sterilization, 1 mL of a 10 g/L biphenyl solution in n-hexane was added on the culture medium to achieve a biphenyl initial concentration of 500 ppm as source of carbon and energy. The evaporation of n-hexane was allowed overnight under a ventilated hood leaving biphenyl crystals suspended in the M284 minimal medium. A relatively homogenous suspension of biphenyl crystals in aqueous phase was achieved by vigorous mixing for 2 min using a mixer (POLYTRON® PT 1200 E, KINEMATICA AG, CH) sterilized by immersion in three successive solutions: SDS 5 %, sodium hypochlorite 4 % and norvanol 9 %. The resulting suspension was inoculated with 3 mL of preculture and incubated at 30 °C (150 rpm orbital agitation). Test controls were also prepared in the same conditions (1) without added NPS nor SiO2 (positive control), (2) with the sole SiO2 matrix (positive control + SiO2), and (3) without inoculum (negative control with or without NPs anchored in SiO2). The negative controls were carried out in triplicates to examine the abiotic removal/evaporation of biphenyl. The optical density was measured at 600 nm (Ultrospec III, Pharmacia LKB) at different time points of incubation (after 3, 8 and 18 days). The interference of nanoparticles on absorbance was corrected with the control samples that contained only nanoparticles to confirm the bacterial growth.
2.3 Biphenyl analysis
Biphenyl residual concentration in the culture medium was measured by HPLC at different time points of incubation (after 3, 8 and 18 days) after liquid–liquid extraction in organic solvent. Glass tubes of a total volume of 10 mL (culture Tube 16 × 100 SVL SCRE, Pyrex®, UK) with Teflon seal and containing 2 mL sample and 4 mL n-hexane were mixed for 24 h at 30 °C. After centrifugation at 7000 rpm (SLA-1500 rotor in Sorvall® RC5B+ centrifuge) for 15 min, the organic phase was transferred in glass tubes for overnight evaporation of solvent under a constant ventilated hood. Crystals of biphenyl were resuspended in 10 mL methanol before analysis by HPLC.
2.4 HPLC analyses
HPLC analyses were performed using an Agilent 1100 Series equipment and a C18 column (LiChroCART® 250 4.6HPLC-cartridge Purospher® STAR RP -18 endcapped 5 μm Merck, D) at 30 °C. The mobile phase contained acetonitrile and Milli-Qwater (resistivity = 18.2 MΩ cm) in the ratio 70/30 in order to determine the biphenyl concentration. Its pH was adjusted to 2.75 with 1.5 M phosphoric acid. The flow rate was 0.8 mL/min, and 10 μL of the sample was injected. Biphenyl was detected at 254 nm, and the concentration in samples was calculated from a standard graph determined using pure compound.
2.5 Enzyme assays
For the enzyme assays needing larger biomass material, the cultures were carried out in 500-mL flasks (in triplicates) with 100 mL of M284 minimal medium complemented by Ag/SiO2, Cu/SiO2, Pd/SiO2 and Co/SiO2 samples or Ag+, Cu2+, Co2+, Pd2+ ions at concentrations of 0 (positive control) or 10−4 M of metal element. The cultures were sterilized for 20 min at 121 °C. After sterilization, 5 mL of 10 g/L biphenyl solution in n-hexane was added as the sole carbon and energy source. The other steps were as described above (Sect. 2.2). After 18 days of incubation, the cells were centrifuged for 20 min at 13,000 rpm at 4 °C and washed twice with a potassium phosphate buffer 0.05 M (K2HPO4, KH2PO4, pH 7.5). The pellets were resuspended in a sufficient volume of the same buffer to obtain a cellular concentration of 0.05 g of wet cells per mL. The cell suspension was then sonicated at a frequency of 10 kHz for 2 min and centrifuged at 13,000 rpm for 40 min. The supernatant containing crude cell-free extracts was used to determine the biphenyl dioxygenase activity and catechol-1,2-dioxygenase activity. During all these operations, the extracts were maintained at 4 °C. For the determination of catechol-1,2-dioxygenase specific activity, a 100 μL volume of concentrated cell-free extracts was added to 900 μL of 0.05 M phosphate buffer (K2HPO4, KH2PO4, pH 7.5) and 20 μL of 10 mM catechol. The specific activity was monitored at 260 nm (ε = 16.8 mM) [50]. The amount of cis, cis-muconic acid formed in the samples was calculated from a standard graph determined using pure compound of cis, cis-muconic acid. One unit of enzyme activity was defined as the amount of enzyme catalyzing the production of 1 μmol cis, cis-muconic acid per min at 30 °C.
2.6 Protein concentration
Protein concentration was measured by the Bradford method [51]. Bovine Serum Albumin (Sigma, USA) was used as a standard.
2.7 Statistical analysis
The SAS software (SAS Institute 2001) was used for all statistical analyses. The general linear model (GLM) was used to determine whether the effect of metal nanoparticles or metal ions was significant on the biodegradation potential of R. erythropolis T902.1. Least square means and standard errors were calculated. A p value of <0.05 was chosen as the threshold for significance of all statistical comparisons.
3 Results and discussion
3.1 Effects of metal nanoparticles (Ag, Cu, Pd and Co) on biphenyl biodegradation
The present study investigates the effect of NPS of about 2–3 nm in diameter of four metals (cobalt, palladium, silver and copper) at a concentration of 10−4 M on biphenyl degradation by R. erythropolis T902.1. These NPS were encapsulated in a porous silica (SiO2) matrix [36–39, 46–48]. Figure 1 shows that the presence of 10−4 M of cobalt NPS, added as Co/SiO2 sample in the culture medium without inoculum, did not exhibit any effect on degradation of biphenyl when compared to the negative control without Co/SiO2 at all time points (p > 0.05). Similar results were recorded with Cu/SiO2, Pd/SiO2 and Ag/SiO2 samples (not shown). Moreover, the presence of the sole SiO2 with inoculum in the culture medium (positive control + SiO2) has no significant inhibitory or stimulating effect on the biphenyl biodegradation by R. erythropolis T902.1 compared to the positive control without SiO2 (p > 0.05) (Fig. 1). Biphenyl was degraded up to 53 ± 1 and at 55 ± 1 %, respectively after 18 days of incubation. These results are in accordance with Mu et al. [52] who reported that SiO2 NPs with sizes of 10–20 nm up to 150 mg/g total suspended solids (estimated at 3.75 × 10−3 M) showed no inhibitory effect on methane generation by anaerobic digestion.
Evolution of a biphenyl concentration and b growth measured by optical density of Rhodococcus erythropolis T902.1 in 100-mL flasks containing 20 mL of M284 culture medium with 500 ppm biphenyl and 10−4 M of calcined (cobalt, palladium, copper or silver) nanoparticles encapsulated in SiO2 matrix by sol–gel method: control (−) and control (−) + Co/SiO2 without microorganisms, control (+) without NP nor SiO2, control (+) + SiO2 without NPS (the % indicated on the figure refer to % of biphenyl degraded). The similar letters (aa, bb, cc and dd) indicate that in the presence of calcined (cobalt, palladium, copper or silver) nanoparticles, no significant statistical differences were observed (p > 0.05) at different time points of biphenyl biodegradation. The error bars means standard deviation on triplicates
Figure 1 indicates also that Ag/SiO2 and Cu/SiO2 samples containing the metallic NPs at 10−4 M effectively reduced the rate of biphenyl degradation as compared to the positive control (p < 0.05). Indeed, silver and copper are widely used as antibacterial agents since they destruct the cell membrane by close contact between the bacteria and these agents (silver and copper) [4, 53–57]. Shahverdi et al. [53] reported that silver and copper bound to cell membranes leading to an increase of permeability and cell death. Other studies [54, 57] indicated that toxicity depends on the particle size. Luna-del Risco et al. [57] tested the influence of particle size of ZnO and CuO on methane production during anaerobic digestion of cattle manure and reported that the inhibitory effects of ZnO and CuO NPs (about 60 and 30 nm size respectively) were much greater than the bulk ZnO and CuO (1 and 5 µm size, respectively). The highest inhibition was recorded for methanogenic microorganisms in presence of NPs with half effective concentration EC50 of about 0.9 × 10−4 and 1.7 × 10−4 M for Zn and Cu NPs, respectively. By comparison, the EC50 were about twofold and tenfold higher for bulk ZnO and CuO particles, respectively, and additionally twofold higher for the other microorganisms involved in the anaerobic digestion process regarding ZnO. Their colleagues [54] confirmed the effect on the yeast strain Saccharomyces cerevisiae. Mu et al. [52] studied the influence of dissolved Zn2+ from ZnO NPs on methane production during waste activated sludge anaerobic digestion and found that the release of Zn2+ from ZnO NPs was an important cause of inhibition of methane production.
In the present study, the metallic Pd, Ag, Cu and Co nanoparticles, with sizes of around 2–3 nm are embedded in inorganic microporous silica particles of around 10–20 nm diameter with pores not exceeding 0.8 nm diameter [38, 46, 47]. Therefore, R. erythropolis cells cannot enter into the SiO2 matrix nor have a direct contact with the metallic NP anchored inside the SiO2 network. Furthermore, the metallic nanoparticles could not release spontaneously outside the SiO2 crystallites as suggested by ICP-AES measurements [10] with Fe2O3/SiO2 samples synthesized by the cogelation method. Indeed, in this study [10], it appears that the amount of Fe3+ ions in an aqueous medium stabilize at around 8 × 10−7 M after 28 days. However, while there is not a full inhibitory effect, the results indicate that Ag/SiO2 and Cu/SiO2 samples with metallic NPs at 10−4 M slow down the biodegradation of biphenyl and the growth of R. erythropolis T902.1 compared to the positive control (p < 0.05) (Fig. 1). However, this bacteria strain is known to produce siderophore compounds in order to complex the metal ions that are essential for its metabolism [58–60]. Our results suggest that these siderophores would not be selective enough and therefore would be able to progressively attract metal ions from the inside of the microporous SiO2 structure. These results should also be related with those reported by Kasemets et al. [54] about copper NPs toxicity on S. cerevisiae, the NPs being directly in suspension in the culture medium and not anchored in silica matrix as in our experiments. They mentioned a 60-fold higher toxicity for CuO nanoparticles (30 nm), i.e., EC50 of about 2 × 10−4 M, than for the bulk copper oxide powder, assuming a cumulative effect of copper solubility and oxidative stress mediated by NPs, since in the normal conditions of viable cells, NPS cannot enter the yeast cells.
By contrast, these siderophores would be favorable in the other experiments reported here since the addition of Co/SiO2 or Pd/SiO2 samples at a metal concentration of 10−4 M induced a significant increase of the biphenyl biodegradation and growth of Rhodococcus strain compared to the positive control (p > 0.05) (Fig. 1). Biphenyl was, respectively, degraded up to 81 ± 1 and 82 ± 4 % after 18 days of incubation. This is in agreement with the results of Sridevi et al. [31] and Kasemets et al. [54] who described the bioavailability of cobalt or palladium as an important factor for enhancement of organic pollutant biodegradation. Sridevi et al. [31] reported that the presence of cobalt up to 1.7 × 10−4 M improves the degradation of phenol. Murugesan et al. [34] showed that the presence of palladium–iron bimetallic NPS up to 0.1 g/L (estimated at 2 × 10−3–2 × 10−6 M, respectively) in minimal salt medium is effective on the complete dechlorination of triclosan (2,4,40-trichloro-20-hydroxydiphenyl ether; up to 27 ppm initial concentration) and biodegradation of the intermediates metabolites by a strain of Sphingomonas genus.
Moreover, our study showed (Fig. 2) that the presence of Co/SiO2 sample at a metal concentration of 10−4 M has a cumulative effect with the improvement of oxygen transfer from ambient air to the liquid culture medium. This is confirmed by the degradation rate achieved during the first 3 days of culture in 250-mL baffled flasks (i.e., 107 ± 3 ppm/day) that was around 15 and 85 % higher than the 93 ± 11 and 58 ± 7 ppm/day achieved in classical culture conditions (100 mL flasks) with or without NPS (p < 0.05). Similar trends were recorded for the biodegradation yields achieved after 18 days of incubation (i.e., 91 ± 1, 81 ± 1 and 53 ± 1 % of biphenyl conversion). However, the biodegradation rate decreased after 3 days. This decrease in the kinetic pattern coincides with the release of soluble metabolites, which gives a yellow color to the medium, indicating that the biphenyl is partially metabolized by R. erythropolis T902.1 [61].
Evolution of a biphenyl concentration and b growth measured by optical density of Rhodococcus erythropolis T902.1 in 100-mL flasks or 250-mL baffled flasks (*) containing 20 mL of M284 culture medium with 500 ppm biphenyl and 10−4 M of calcined cobalt nanoparticles encapsulated in SiO2 matrix by sol–gel method. The similar letters (aa, bb, cc and dd) indicate that in the presence of nanoparticles, no significant statistical differences were observed (p > 0.05) at different time points of biphenyl biodegradation. The error bars means standard deviation on triplicates
The physico-chemical properties, such as the specific surface area, S BET, the size of silica particles, \(d_{{{\text{SiO}}_{2} }}\), the size of metallic nanoparticles, d MX+, (Table 1) of Cu/SiO2, Co/SiO2, Ag/SiO2 and Pd/SiO2 samples could have an important impact on the biphenyl degradation by Rhodococcus. Pd/SiO2 sample has the smallest \(d_{{{\text{SiO}}_{2} }}\) but the greatest S BET (i.e., 13 nm and 495 m2/g, respectively). By comparison, Co/SiO2 sample presents the smallest S BET (i.e., 75 m2/g), while \(d_{{{\text{SiO}}_{2} }}\) is equal to 25 nm. These significant differences and the similar d MX+ of all the tested NPs suggest that no real impact of d MX+, \(d_{{{\text{SiO}}_{2} }}\) or the S BET might be related to the biphenyl degradation rate by Rhodococcus in presence of Co/SiO2 and Pd/SiO2 samples. Moreover, these properties could not explain the lower biphenyl degradation rate recorded in presence of Ag/SiO2 and Cu/SiO2 samples since they are of the same order than those of Pd/SiO2 sample.
3.2 Effect of different concentrations of Co2+ ions and Co/SiO2 sample on biphenyl biodegradation
The improvement effect of different forms of Co/SiO2 sample (i.e., dried, calcined and reduced) and Co2+ ions at different cobalt concentrations, i.e., 10−6, 10−5 or 10−4 M was studied. The results show that the biphenyl biodegradation yields increased with the concentration of Co/SiO2 sample present in the vessels, whatever Co/SiO2 sample is dried, calcined and/or reduced (Table 2). Significantly different yields were observed when the cobalt concentration is decreased from 10−5 to 10−6 M. However, the yields were similar in the presence of Co/SiO2 sample at 10−5 and 10−4 M of cobalt, biphenyl being degraded up to about 80 % after 18 days of incubation. This suggests that an excess of cobalt up to 10−4 M has no real impact on the efficiency of biphenyl bioconversion except with the reduced cobalt NPS yielding at 77 ± 2 % instead of about 82 % with both the other calcined or dried forms (Table 2). Indeed, in dried Co/SiO2 sample, the oxidation state of cobalt is 2+ and in calcined Co/SiO2 sample, the oxidation states can be 2+ or 3+ because these nanoparticles are present as metallic oxide in the form Co3O4 [62]. In contrast, the oxidation state of cobalt is zero in reduced Co/SiO2 sample. The effect of these differences in cobalt oxidation state on biphenyl biodegradation should be further investigated and also in relation with the availability of the cobalt-containing compounds as highlighted by Santos et al. [63] demonstrated that the presence of different forms of solubles iron at the concentrations of 10−4 M (FeCl3, Fe(NO3)3, Fe2O3, FeSO4) had a positive impact on biodegradation of anthracene by pseudomonas sp with up to 25 % higher biodegradation yield than in the iron nitrate.
The effect of CoCl2 was also studied using the same concentrations tested for Co/SiO2 sample. The results show that CoCl2 has a strong positive effect on the efficiency of biphenyl biodegradation at different concentrations ranging from 10−6 to 10−4 M (Table 2) compared to the cultures with Co/SiO2 sample. This is consistent with an improvement effect due to a higher solubility of the benefic metallic element as reported by Santos et al. [63]. By contrast, Yeom and Yoo [64] achieved a complete inhibition of benzene and toluene biodegradation by Alcaligenes xylosoxipans Y234 in presence of cobalt at a concentration of 2.5 × 10−4 M. Kotresha and Vidyasagar [29] also reported a twofold decrease of phenol degradation rate by Pseudomonas aeruginosa MTCC 4996 in the presence of 2 × 10−4 M of cobalt compared to 2.5 × 10−5 M.
3.3 Effect of different concentrations of silver and copper ions (Ag+ or Cu2+) and Ag/SiO2 or Cu/SiO2 samples on biphenyl biodegradation
Table 3 shows that the presence of Cu/SiO2 or Ag/SiO2 sample in the culture medium at a metal concentration from 10−5 to 10−4 M leads to about 20 % lower biphenyl degradation yields compared to the positive control (p < 0.05), while no significant effect was recorded at a concentration of 10−6 M. In addition, Table 3 shows significantly higher negative impact in presence of silver and copper ions at the same concentrations. Furthermore, the effect was already measurable at 10−6 M of Ag+ ions. Therefore, it can be assumed that, since the metallic NPs were anchored in silica, the Ag/SiO2 and Cu/SiO2 samples were less toxic toward bacteria at similar concentrations than the tested copper chloride or the silver nitrate. These results are consistent with those of the literature attributing metal toxicity to the dissolved ions [65] and reporting inhibition of different bacterial metabolisms at concentrations of about 2 × 10−5 M of soluble copper [59, 66]. Additionally, the encapsulation of the metal NPs inside the porous silica matrix would limit the metal availability in the bacterial environment even when influenced by the suggested siderophore mechanism (Sect. 3.1).
On the other hand, Table 3 shows that the Ag+ ions effectively reduced the biphenyl degradation yields at all tested concentrations (10−6, 10−5 or 10−4 M) as compared to the Cu2+ ions, whereas, at a same concentration, similar yields were recorded for both anchored NPs in silica. Moreover, the lowest degradation yield recorded in presence of Ag/SiO2 (40 ± 1 % at 10−4 M Ag) was still higher than the 33 ± 1 % measured at 10−6 M Ag+. These results highlight the tremendous toxicity of Ag+ ions on the potential of the R. erythropolis T902.1 for biphenyl degradation compared to the Cu2+ ions and the encapsulated NPs. Furthermore, it is to mention that Kuo and Sharak Genthner [65] reported a positive effect of Cu2+ ions at 0.01 ppm (i.e., about 10−7 M) on the degradation of benzoate, 2-chlorophenol and both phenol and benzoate by anaerobic bacterial consortia.
Despite low concentrations of Cu2+ ions are essential for bacteria since they provide vital cofactors for metalloproteins and enzymes [67], these ions have an inhibitory action on bacteria by blocking essential functional groups, replacing other essential metal ions, or modifying the active conformation of biological molecules [68]. However, the bacteria have different strategies to deal with toxic metal concentration in the environment [69]. These strategies can be divided into two classes: (1) prevent entry of the metal into the cell and (2) actively pump the toxic metal out of the cell [70].
3.4 Effect of metallic ions (Co2+, Ag+ or Cu2+) and the nature of Co/SiO2, Ag/SiO2 or Cu/SiO2 samples on catechol 1,2-dioxygenase activity
Various aerobic bacteria catabolism of PAH involve two key steps that are (1) the activation of the aromatic ring and (2) its subsequent cleavage [71]. Dioxygenase enzymes are responsible for the conversion of these compounds by adding molecular oxygen to the ring. In the case of biphenyl metabolism, these enzymes are called biphenyl dioxygenases [72]. In the second step, catechol dioxygenases are responsible to open the ring through ortho or meta oxidation, i.e., the catechol 1,2-dioxygenase plays a central role in the cleavage of the aromatic ring of catechol to cis, cis-muconic acid in presence of 1 mol of oxygen [50, 73]. The biodegradation mechanism of biphenyl is well characterized in several bacterial strains such as Burkholderia xenovorans LB400 [74], Achromobacter sp. BP3 [61] and Rhodococcus sp. [25, 67, 75]. Takeda et al. [25] proposed the major pathway for the Rhodococcus sp. strain RHA1 as follows: biphenyl oxidation to 2,3-dihydroxybiphenyl by 1,2-dioxygenase, followed ring cleavage to form 2-hydroxy-6-oxo-6-phenylhexa-2,4-dienoate, which is then cleaved to benzoate and 2-hydroxypenta-2,4-dienoate. The effects of dissolved metallic ions or metal NPS encapsulated in porous silica matrix were investigated on the activity of catechol 1,2-dioxygenase. The results are shown in Fig. 3. The Co2+ ions or Co/SiO2 sample at 10−4 M of metal has a slight positive effect on the efficiency of enzyme activity (p < 0.05). By contrast, the results indicated that the addition of 10−4 M of Ag+ or Cu2+ ions or Ag/SiO2 or Cu/SiO2 samples inhibited the enzymatic reaction as compared to the positive control (p < 0.05). These trends are in accordance with the results discussed in the former sections regarding the biphenyl biodegradation yields. They confirm some experimental data reported in the literature. Nadaf and Ghosh [50] showed that the activity of catechol 1,2-dioxygenase was minimally affected by Co2+ ions for concentrations lower than 10−3 M, whereas the enzymatic reaction was completely inhibited by the addition of 10−3 and 10−2 M of Co2+ ions. Similarly, Yeom and Yoo [64] reported that silver ions at low concentrations have a strong inhibitory effect on the catechol 1,2-dioxygenase.
Effect of 10−4 M of calcined (cobalt, copper or silver) nanoparticles encapsulated in SiO2 matrix by sol–gel method or (cobalt, copper or silver) ions on catechol 1,2-dioxygenase activity. Different letters above histograms means that the results are significantly different from the control (p < 0.05). The error bars means standard deviation on triplicates
4 Conclusions
The present study investigates the potential of the R. erythropolis T902.1 to biodegrade biphenyl in the presence of encapsulated metals (Co/SiO2, Pd/SiO2, Ag/SiO2 or Cu/SiO2) inside a porous silica matrix and metallic ions (Co2+, Cu2+ or Ag+) at different concentrations 10−6, 10−5 or 10−4 M. Biodegradation experiments found that silver ions are the most toxic to the R. erythropolis T902.1, already at a concentration of 10−6 M. The presence of 10−5 or 10−4 M of Cu2+ ions has also an inhibitory effect on the microbial metabolism and particularly on the activity of catechol 1,2-dioxygenase, a major enzyme involved in the biodegradative pathways of biphenyl.
By contrast, the results show a strong positive effect of Co2+ ions on biphenyl biodegradation at different concentrations with a 70 % higher degradation yield recorded at 10−4 M of Co2+ compared with the control conditions without metal ions of cobalt. On the other hand, the results indicate that the addition of Co/SiO2 or Pd/SiO2 samples at the same 10−4 M of metal concentration also stimulates biphenyl biodegradation with around 30 % higher degradation yield than in control conditions. The highest biphenyl biodegradation rate and yield, i.e., 107 ± 3 and 91 ± 1 % ppm/day, respectively, were recorded in 250-mL baffled flasks stirred at 150 rpm with 10−4 M of Co/SiO2 sample. They are about 85 and 70 % higher than in control conditions without NPS. As a consequence, two advantages are suggested for the use of metallic NPs encapsulated inside silica matrix in order to improve R. erythropolys activity: the encapsulation by sol–gel method (1) prevents agglomeration of the active sites, maintaining a high specific surface area and (2) limits the availability of the anchored elements to the microorganisms able to produce siderophore-like molecules for catching them.
References
Drug Product Database (2013). Ottawa: health Canada. http://www.hc-sc.gc.ca/dhp-mps/prodpharma/databasdon/index-fra.php. Accessed 28 May 2013
Borja J, Taleon DM, Auresenia J, Gallardo S (2005) Process Biochem 40:1999–2013
Wei G, Yu J, Zhu Y, Chen W, Wang L (2008) J Hazard Mater 151:111–117
Lin CW, Chen SY, Cheng YW (2006) J Biochem Eng 32:25–32
Esen F, Tasdemir Y, Vardar N (2008) Atmos Res 88:243–255
Wang L, Lin L, Lai S (2009) J Hazard Mater 186:438–444
Alkurdi F, Karabet F, Dimashki M (2014) Environ Sci Pollut Res 21:5747–5759
Bunescu A, Besse-Hoggan P, Sancelme M, Mailhot G, Delort AM (2008) Appl Environ Microbiol 74:2976–2984
Tsormpatsidis E, Henbest RGC, Battey NH, Hadley P (2010) Ann Appl Biol 156:357–366
Mahy JG, Tasseroul L, Zubiaur A, Geens J, Brisbois M, Herlitschke M, Hermann R, Heinrichs B, Lambert SD (2014) Microporous Mesoporous Mater 197:164–173
Chorao C, Charmantray F, Besse-Hoggan P, Sancelme M, Cincilei A, Traïkia M, Mailhot G, Delort AM (2009) Chemosphere 75:121–128
Aldric JM, Thonart P (2008) J Chem Technol Biotechnol 83:1401–1408
Nair CI, Jayachandran K, Shashidhar S (2008) Afr J Biotechnol 7:4951–4958
Watanabe K (2001) Curr Opin Biotechnol 12:231–241
Tandlich R, Vrana B, Payne S, Dercová K, Balaz S (2011) J Environ Sci Health A Tox Hazard Subst Environ Eng 46:337–344
Arun A, Raja PP, Arthi R, Ananthi M, Kumar KS, Eyini M (2008) Appl Biochem Biotechnol 151:132–142
Kumara M, Leon V, De Sisto Materano A, Ilzins OA, Galindo-Castro I, Fuenmayor SL (2006) Z Naturforsch C 61:203–212
Kim SJ, Kweon O, Cerniglia CE (2010) In: Timmis KN (ed) Handbook of hydrocarbon and lipid microbiology. Springer, Berlin
Dandie CE, Thomas SM, Bentham RH, McClure NC (2004) J Appl Microbiol 97:246–255
Kim SJ, Kweon O, Freeman JP, Jones RC, Adjei MD, Jhoo JW, Edmondson RD, Cerniglia CE (2006) Appl Environ Microbiol 72:1045–1054
Saito A, Iwabuchi T, Harayama S (2000) J Bacteriol 182:2134–2141
Grishchenkov VG, Slepenkin AV, Boronin AM (2002) Appl Biochem Microbiol 38:125–128
Takeo M, Murakami M, Niihara S, Yamamoto K, Nishimura M, Kato DI (2008) J Bacteriol 190:7367–7374
Davoodi-Dehaghani F, Vosoughi M, Ziaee AA (2010) Bioresour Technol 101:1102–1105
Takeda H, Yamada A, Miyauchi K, Masai E, Fukuda M (2004) J Bacteriol 186:2134–2146
Díaz E (2004) J Int Microbiol 7:173–180
Iwanade A, Jang JH, Hirai M, Shoda M (2005) Environ Technol 26:941–949
Loh KC, Chung TS, Wei-Fern A (2000) J Environ Eng 126:75–79
Kotresha D, Vidyasagar GM (2008) World J Microbiol Biotechnol 24:541–547
Aldric JM, Destain J, Thonart P (2003) In: Proceedings of environment 2010: situation and perspectives for the European Union. 6–10 May, Porto
Sridevi V, Chandana Lakshmi MVV, Swamy AVN, Narasimha Rao M (2011) J Bioremediat Biodegrad 2:114–221
Beckers L, Hiligsmann S, Lambert SD, Heinrichs B, Thonart P (2013) Bioresour Technol 133:109–117
Zhang WX (2003) J Nanopart Res 5:323–332
Murugesan K, Bokare V, Jeon JR, Kim EJ, Kim JH, Chang YS (2011) Bioresour Technol 102:6019–6025
Eduok S, Martin B, Villa R, Nocker A, Jefferson B, Coulon F (2013) Ecotoxicol Environ Saf 95:1–9
Kaiser A, Görsmann C, Schubert U (1997) J Sol Gel Sci Technol 8:795–799
Heinrichs B, Lambert S, Job N, Pirard JP (2007) In: Regalbuto JR (ed) Catalyst preparation: science and engineering. CRC Press, Boca Raton
Lambert SD, Tran KY, Arrachart G, Noville F, Henrist C, Bied C, Moreau JJE, Man MWC, Heinrichs B (2008) Microporous Mesoporous Mater 115:609–617
Heinrichs B, Rebbouh L, Geus JW, Lambert SD, Abbenhuis HCL, Grandjean F, Long GJ, Pirard JP, van Santen RA (2008) J Non-Cryst Solids 354:665–672
Pirard S, Mahy J, Pirard JP, Heinrichs B, Raskinet L, Lambert SD (2015) Microporous Mesoporous Mat 209:197–207
Alié C, Pirard JP (2003) J Non-Cryst Solids 320:21–30
Alié C, Pirard R, Pirard JP (2003) J Non-Cryst Solids 320:31–39
Heinrichs B, Beketov G, Lambert SD, Geus JW, Kruse N, Pirard JP (2006) Stud Surf Sci Catal 162:521–528
Heinrichs B, Geus JW, Lambert SD, Pirard JP (2006) J Catal 241:229–231
Gommes CJ, de Jong K, Pirard JP, Blacher S (2005) Langmuir 21:12378–12385
Lambert SD, Cellier C, Grange P, Pirard JP, Heinrichs B (2004) J Catal 221:335–346
Lambert SD, Alié C, Pirard JP, Heinrichs B (2004) J Non-Cryst Solids 342:70–80
Lambert SD, Polard J-F, Pirard J-P, Heinrichs B (2004) Appl Catal B Environ 50:127–140
Weekers F, Jacques P, Springael D, Mergeay M, Diels L, Thonart P (1999) Appl Biochem Biotechnol 77:251–266
Nadaf NH, Ghosh JS (2011) Environ Earth Sci 3:608–613
Bradford MM (1976) Anal Biochem 72:248–254
Mu H, Chen Y, Xiao N (2011) Bioresour Technol 102:10305–10311
Shahverdi AR, Fakhimi A, Shahverdi HR (2007) Nanomed Nanotechnol Biol Med 3:168–171
Kasemets K, Ivask A, Dubourguier HC, Kahru A (2009) Toxicol In Vitro 23:1116–1122
Gao QH (2011) The tolerance of a Rhodococcus drinking water isolate and Zoogloea ramigera to silver nanoparticles in biofilm and planktonic cultures. Thesis of the Faculty of the Graduate School, University of Texas, Austin
Bagchi B, Dey S, Bhandary S, Das S, Bhattacharya A, Basu R, Nandy P (2012) Mater Sci Eng 32:1897–1905
Luna-del Risco M, Orupold K, Dubourguier HC (2011) J Hazard Mater 189:603–608
Carrano CJ, Jordan M, Drechsel H, Schmid DG, Winkelmann G (2001) Biometals 14:119–125
Kraemer SM (2004) Aquat Sci 66:3–18
Bosello M, Zeyadi M, Kraas FI, Linne U, Xie X, Marahiel MA (2013) J Nat Prod 76:2282–2290
Hong Q, Dong X, He L, Jiang X, Li S (2009) Int Biodeterior Biodegrad 63:365–370
Vasconcelos DCL, Nunes EHM, Houmard M, Motuzas J, Nascimento JF, Grava W, Ciminelli VST, da Costa JCD, Vasconcelos WL (2013) J Non-Cryst Solids 378:1–6
Santos EC, Jacques RJS, Bento FM, Peralba MCR, Selbach PA, Sà EL, Camargo FA (2008) Bioresour Technol 99:2644–2649
Yeom SH, Yoo Y (1997) J Chem Eng 14:204–208
Wong SW, Leung PT, Djurisic AB, Leung KM (2010) J Anal Bioanal Chem 396:609–618
Kuo CW, Sharak-Genthner BR (1996) Appl Environ Microbiol 62:2317–2323
Chua H, Sin SN, Cheung MW (1999) Chemosphere 39:2681–2692
Rajapaksha RM, Tobor-Kapłon MA, Bååth E (2004) Appl Environ Microbiol 70:2966–2973
Nies DH (2003) Microbiol Rev 27:313–339
Roanne TM, Pepper IL (2000) J Biochem 123:16–23
Ohmori T, Morita H, Tanaka M, Miyauchi K, Kasai D, Furukawa K, Miyashita K, Ogawa N, Masai E, Fukuda M (2011) J Biosci Bioeng 111:437–442
Suenaga H, Watanabe T, Sato M, Ngadiman, Furukawa K (2002) J Bacteriol 184:3682–3688
Zaki S (2006) J Sci Environ Manag 10:75–81
Rehmann L, Daugulis AJ (2006) Chemosphere 63:972–979
Sakai M, Miyauchi K, Kato N, Masai E, Fukuda M (2003) Appl Environ Microbiol 69:427–433
Acknowledgments
Wissal Wannoussa is grateful for Damascus University-Syria for their Grant supported correspondence. S. D. L. is grateful to F.R.S.-F.N.R.S for her research associate position. T. M. is also grateful to F.R.I.A for his PhD thesis Grant. The authors are grateful to Dr Nassim Moula for his contribution on statistical analyses in this study. The authors acknowledge the Ministère de la Région Wallonne Direction Générale des Technologies, de la Recherche et de l’Energie and the Fonds de Recherche Fondamentale Collective for financial supports.
Author information
Authors and Affiliations
Corresponding author
Additional information
Serge Hiligsmann contributed equally to this work.
Rights and permissions
About this article
Cite this article
Wannoussa, W., Hiligsmann, S., Tasseroul, L. et al. Effect of metal ions and metal nanoparticles encapsulated in porous silica on biphenyl biodegradation by Rhodococcus erythropolis T902.1. J Sol-Gel Sci Technol 75, 235–245 (2015). https://doi.org/10.1007/s10971-015-3694-4
Received:
Accepted:
Published:
Issue Date:
DOI: https://doi.org/10.1007/s10971-015-3694-4